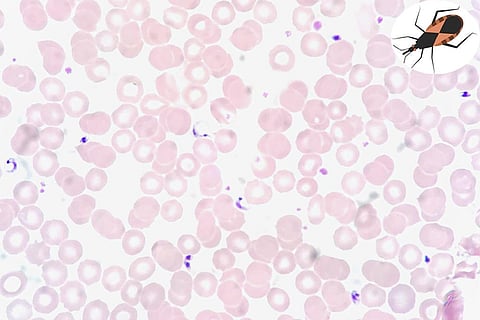
फोटो साभार : विकिमीडिया कॉमन्स,एड उथमन

विश्व स्वास्थ्य संगठन ने 14 अप्रैल को विश्व चगास रोग दिवस के रूप में घोषित किया है। इस दिन इस बीमारी से जूझ रहे सभी लोगों के लिए स्वास्थ्य देखभाल और सेवाओं तक समान पहुंच का आह्वान किया जाता है।
इस दिन का उद्देश्य चगास नामक बीमारी के साथ रहने वाले लोगों की वास्तविकता और इसके परिणामों के बारे में जागरूकता बढ़ाना है, ताकि 2030 तक डब्ल्यूएचओ के सदस्य देशों द्वारा निर्धारित लक्ष्य को हासिल किया जा सके। जैसा कि नजरअंदाज की गई बीमारियों के लिए रोडमैप में कहा गया है, एक सार्वजनिक स्वास्थ्य समस्या के रूप में चगास का उन्मूलन करना जरूरी है।
यह चागास रोग को प्राथमिक स्वास्थ्य देखभाल में शामिल करने का समय है। चगास रोग के कई देशों में पहचान की दर 10 फीसदी से भी कम है। इसके कारण इसके रोगियों को पर्याप्त स्वास्थ्य सेवा तक पहुंचने में लगातार बाधाएं होती हैं। चगास रोग महाद्वीपीय लैटिन अमेरिका की गरीब आबादी के बीच प्रचलित है लेकिन अब यह अन्य देशों और महाद्वीपों में तेजी से पाया जा रहा है।
इसे अक्सर "साइलेंट एंड साइलेंट डिजीज" कहा जाता है क्योंकि अधिकांश संक्रमित लोगों में कोई लक्षण या बहुत हल्के लक्षण होते हैं। विश्व स्वास्थ्य संगठन (डब्ल्यूएचओ) के अनुसार, दुनिया भर में चगास रोग से लगभग 60 से 70 लाख लोग संक्रमित होते हैं, जिनमें से हर साल 12 हजार की मौत हो जाती हैं। लगभग 7.5 करोड़ लोगों को इस रोग के संक्रमण होने का खतरा रहता है।
क्या होता है चगास रोग?
चगास रोग, जिसे अमेरिकन ट्रिपैनोसोमियासिस के रूप में भी जाना जाता है, प्रोटोजोआ परजीवी, ट्रिपैनोसोमा क्रूज़ी के कारण होता है। ये परजीवी मुख्य रूप से संक्रमित रक्त-चूसने वाले ट्रायटोमाइन कीड़ों के मल, मूत्र के संपर्क में आने से फैलते हैं - इसे वेक्टरियल ट्रांसमिशन कहा जाता है।
ये कीड़े आम तौर पर ग्रामीण और उपनगरीय क्षेत्रों में समान रूप से घरों की दीवार या छत की दरारों और चिकन कॉप्स, पेन और गोदामों जैसे संरचनाओं में रहते हैं।
आम तौर पर, वे दिन के दौरान छिपते हैं, केवल रात में सक्रिय होते हैं जब वे जानवरों और लोगों के खून को भोजन के रूप में चूसते हैं। ट्रायटोमाइन कीट आमतौर पर चेहरे जैसे त्वचा के खुले क्षेत्र को काटता है, इसलिए इसका सामान्य नाम "किसिंग बग" है। यह कीट काटने के दौरान शौच या पेशाब करता है।
परजीवी शरीर में प्रवेश करते हैं जब व्यक्ति सहज रूप से बग के मल या मूत्र या काटने में, अन्य त्वचा में छेद कर देता है, या आंखों या मुंह में डालता है। यह रोग दूषित भोजन के माध्यम से भी फैलता है।
सदियों से, यह रोग लैटिन अमेरिकी में ग्रामीण आबादी की एक समस्या रही है। हालांकि, बैक्टीरियल ट्रांसमिशन को नियंत्रित करने में सफलताओं के साथ-साथ ग्रामीण से शहरी क्षेत्रों में बड़े पैमाने पर आबादी के जाने और अंततः महाद्वीपों में, अन्य ट्रांसमिशन चैनलों की प्रासंगिकता में वृद्धि हुई है, जैसे कि रक्त आधान, जन्मजात संचरण और यहां तक कि अंग प्रत्यारोपण आदि से।
क्या है चगास रोग का उपचार?
चगास रोग के खिलाफ वर्तमान में कोई टीका नहीं है। जन्मजात संचरण को रोकने के लिए संक्रमण लड़कियों और प्रसव उम्र की महिलाओं में इसका पता लगाने के साथ-साथ डोमिसिलरी बैक्टीरियल कंट्रोल और ट्रांसफ्यूजन और ट्रांसप्लांटेशन स्क्रीनिंग लैटिन अमेरिका में सबसे प्रभावी रोग नियंत्रण उपाय हैं।